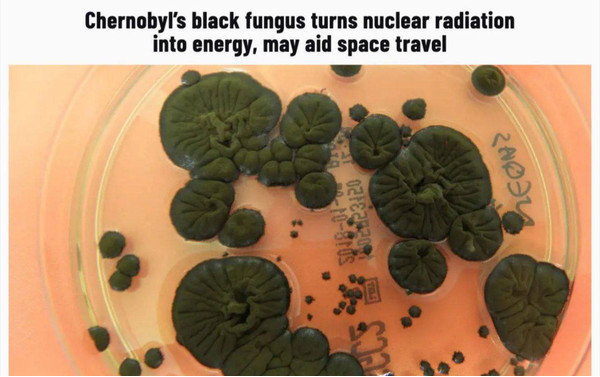

Вчені вважають, що це відкриття здатне кардинально змінити підходи до захисту і будівництва в космосі.
Вони вивчають грибок Cladosporium sphaerospermum, який завдяки меланіну здатний рости під впливом радіації і частково її поглинати.
Такий біологічний щит можна вирощувати прямо в космосі, що робить його більш легкою і дешевою альтернативою традиційним захисним матеріалам.
NASA вже розглядає концепцію «мікоархітектури» — самовідновлюваних міцелієвих конструкцій, які можуть стати основою майбутніх позаземних поселень.
